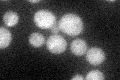
YIL154C
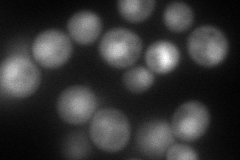
YIL154C
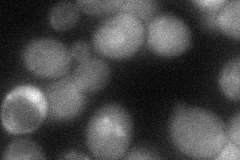
YIL154C
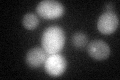
YIL154C
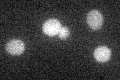
YIL154C

View description
Transcriptional activator involved in maintenance of ion homeostasis and protection against DNA damage caused by bleomycin and other oxidants, contains a C-terminal leucine-rich repeat
Localization:
Intensity:
Fold change:
Significance:
-
C’ GFP library in SD
cytosol26.47 -
N' NOP1pr-GFP in SD

cytosol,nucleus98.6817 -
N' TEF2pr-mCherry in SD
nucleus95.9741 -
N' NATIVEpr-GFP in SD

below threshold24.2823 -
N' TEF2pr-VC and Cyto-VN in SD
cytosol37.125 -
C’ GFP library in SD+DTT
cytosol29.321.1No -
C’ GFP library in SD+H2O2

cytosol28.491.07No -
C’ GFP library in Starvation Media
cytosol34.841.31No -
C’ GFP library on the background of Pup2-DaMP

cytosol -
C’ GFP library on the background of CCT mutant

cytosol25.08890.947452No
